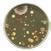

Biología y Geología


Bachillerato

![]()



Radix es la nueva propuesta de Editorial Casals para ESO y Bachillerato.
Una invitación a reconectar con el sentido profundo del aprendizaje y a crecer desde lo esencial.
Raíz, conocimiento y desarrollo.
Un proyecto sólido, actual y claramente alineado con la educación de hoy.
Geología ESO

Situaciones de aprendizaje
Seis propuestas por curso que parten de contextos reales para conectar los saberes con el entorno de los alumnos.
Cada situación incorpora actividades y recursos que permiten construir y resolver el reto de manera progresiva y guiada.
Una secuencia didáctica centrada en explorar, explicar, elaborar, aplicar y evaluar para favorecer un aprendizaje activo.
Alfabetización científica

claves del proyecto
Propuestas para interpretar datos, para argumentar con rigor y para formar opiniones basadas en evidencias.
Investigaciones científicas
Vídeos y prácticas guiadas que acercan la experimentación al aula y que potencian la observación y la indagación.
ideas
Organizadores visuales que sintetizan los conceptos clave, facilitan el repaso y fomentan la autonomía de los alumnos.
Presencia de científicas y científicos de distintas disciplinas para mostrar una ciencia diversa, actual y en constante evolución.
Pensamiento computacional
Actividades para analizar problemas, para identificar patrones y para diseñar soluciones paso a paso, aplicadas a contextos científicos y a situaciones reales.
Biología y Geología ESO

Biología y Geología 1
ISBN papel: 978-84-218-8326-6
ISBN digital: 978-84-218-8500-0
¡NOVEDAD!

Biology and Geology 1
ISBN papel: 978-84-218-8327-3
ISBN digital: 978-84-218-8501-7
¡NOVEDAD!
¡Descubre
el proyecto!
Accede a una muestra digital.

Biología y Geología 3
ISBN papel: 978-84-218-8329-7
ISBN digital: 978-84-218-8503-1
¡NOVEDAD!

Biology and Geology 3
ISBN papel: 978-84-218-8330-3
ISBN digital: 978-84-218-8504-8
¡NOVEDAD!

Biología y Geología 4
ISBN papel: 978-84-218-8575-8
ISBN digital: 978-84-218-8716-5
Próximo curso 2027-2028

Biology and Geology 4
ISBN papel: 978-84-218-8576-5
ISBN digital: 978-84-218-8717-2
Próximo curso 2027-2028
Disponible también en inglés para centros bilingües
Más de 800 recursos digitales para enriquecer tus clases y motivar al alumnado.


Ruta de aprendizaje
«Evaluación inicial», «Mejora» y «Ponte a prueba»: un itinerario que promueve un aprendizaje activo, continuo y formativo.
«Laboratorio en casa»
Grabaciones específicas que permiten observar prácticas experimentales cuando no es posible realizarlas en el aula.
Vídeos
Recursos que facilitan la comprensión de los contenidos teóricos y que muestran ejemplos reales de procesos geológicos y biológicos.
Experiencias activas, inmersivas y motivadoras que permiten aclarar conceptos complejos y simular fenómenos naturales.
Soportes visuales que facilitan la interpretación de ilustraciones, procesos biológicos y geológicos e infografías.
materiales y recursos para el alumnado
1
Presentación de la situación de aprendizaje y del reto
Se presentan el contexto, los objetivos de aprendizaje, el recorrido de saberes que seguirá el alumnado y el reto final que orienta todo el proceso.
¿Las


los roles para completar hoja de contrato del trabajo cooperativo.
1. ¿Qué damos al donar sangre? ¿Puedo donar sangre? Sin duda no habrás donado sangre todavía porque
tu barrio, pueblo ciudad. Pero ¿qué damos exactamente cuando donamos sangre? aReflexiona sobre las siguientes cuestiones relacionadas con las donaciones de sangre. A. Conoces alguien que
2
Construcción del conocimiento
Bloques de contenido con un contexto de introducción, conceptos teóricos, actividades para practicar y actividades en contexto para aplicar los saberes a la vida real.
y 4) defender nuestro organismo. Las tres primeras funciones son imprescindibles para la supervivencia de un ser vivo.
Ítem 2. ¿Todos los organismos tienen sangre? Como ya debes de haber visto









3 Evaluación y regulación del aprendizaje
Propuestas orientadas a la regulación del proceso de aprendizaje y a la calificación de las competencias específicas y de las competencias clave.
Actividad experimental diseñada para aplicar los conocimientos trabajados y para favorecer el desarrollo de habilidades científicas. 4 Práctica de laboratorio

6 «Ciencia en acción» y «Resolvemos el reto»
Actividades finales orientadas a la resolución del reto, con regulación del aprendizaje y evaluación de las competencias específicas y las competencias clave.

Síntesis gráfica de los contenidos clave trabajados, que facilita la comprensión global, la organización de las ideas y la consolidación de los aprendizajes.







Adaptación curricular
Biología y Geología ESO



Biología y Geología 1
ISBN papel: 978-84-218-8430-0
¡NOVEDAD!
Biología y Geología 3
ISBN papel: 978-84-218-8433-1
¡NOVEDAD!
Aprende lo básico, el recurso del docente para adaptar los saberes y para acompañar en los distintos ritmos de aprendizaje.
Cuaderno fotocopiable
Biología y Geología 4
ISBN papel: 978-84-218-8622-9
Próximo curso 2027-2028
Con la misma estructura y metodología que el libro del alumnado
Con solucionario y en versión digital



Todo lo que necesitas para planificar, acompañar y evaluar el aprendizaje, en tu Propuesta didáctica.


Orientaciones prácticas
Pautas metodológicas e itinerarios de personalización del aprendizaje que garantizan la inclusión de todos los alumnos. Ofrece refuerzos, ampliaciones y solucionario completo.
Programación de aula
Criterios de evaluación, competencias específicas y competencias clave, y actividades organizadas por sesiones.
Rúbricas de evaluación
Herramientas claras para valorar el progreso y las competencias del alumnado. Autoevaluación, coevaluación y heteroevaluación.
Generador de exámenes
Para crear pruebas personalizadas basadas en criterios de evaluación y en competencias. Incluye modelos sugeridos por situación de aprendizaje y por trimestre.
Guía de recursos digitales
Explicación del uso y de la finalidad de todas las herramientas.
Gestión de aula eCasals
Libro digital y seguimiento individual de los alumnos desde un único entorno.


Contenidos organizados en contextos que permiten trabajar los saberes del área de manera integrada y significativa.

Ejercicios competenciales centrados en la gestión de la información, en la resolución de problemas y en el pensamiento crítico.
Cada idea clave se inicia con una pregunta que activa los conocimientos previos y orienta el aprendizaje.
Aprender resolviendo retos
Los retos estructuran cada situación de aprendizaje con actividades que guían la construcción del conocimiento y su resolución progresiva.

Rigor científico actualizado
Contenidos revisados con datos actuales, lenguaje preciso y uso adecuado del vocabulario científico.
Pensamiento científico
Trabajo sistemático de la formulación de hipótesis, análisis de datos, interpretación de gráficos y argumentación científica.
Representación visual
Esquemas, infografías y recursos visuales que facilitan la comprensión de procesos complejos.
claves del proyecto
Ciencia en el mundo real
Referencias a la investigación, a la universidad y al mundo profesional para dar sentido a la materia.
Biología, Geología y Ciencias Ambientales BA

Biología, Geología y Ciencias Ambientales
ISBN papel: 978-84-218-8400-3
ISBN digital: 978-84-218-8562-8
¡NOVEDAD!
¡Descubre el proyecto!
Accede a una muestra digital.

Biología 2
ISBN papel: 978-84-218-8682-3
ISBN digital: 978-84-218-8774-5
Próximo curso 2027-2028
Más de 100 recursos digitales para enriquecer tus clases y motivar al alumnado.


Ruta de aprendizaje
«Evaluación inicial», «Mejora» y «Ponte a prueba»: un itinerario que promueve un aprendizaje activo, continuo y formativo.
Vídeos
Recursos que facilitan la comprensión de los contenidos teóricos y que muestran ejemplos reales de procesos biológicos y geológicos.
Interactivos
Experiencias activas, inmersivas y motivadoras que permiten aclarar conceptos complejos y simular fenómenos naturales.
Animaciones
Soportes visuales que facilitan la interpretación de ilustraciones, procesos biológicos y geológicos e infografías.
Documentación complementaria
Materiales de apoyo para realizar y ampliar las actividades propuestas.
materiales y recursos para el alumnado
Podéis resolver este reto de forma cooperativa. Para organizaros, descargad los documentos adjuntos.
Presentación de la situación de aprendizaje y del reto
Se presentan el contexto, los objetivos de aprendizaje, el recorrido de saberes que seguirá el alumnado y el reto final que orienta todo el proceso.

El 28 % de los animales de nuestro planeta están en peligro de extinción. Un animal se considera en peligro de extinción cuando todos los representantes de su especie corren el peligro de desaparecer de su hábitat. La Unión Internacional para la Conservación de la Naturaleza (UICN) elabora todos los años una lista roja de especies en la que figuran los animales con mayor índice de probabilidad de desaparición. Esta lista es un indicador crítico de la salud de la biodiversidad del mundo.
El lince ibérico Lynx pardinus es una especie de mamífero carnívoro endémico de la península ibérica que fue considerado por
UICN como uno de los felinos más amenazados del mundo. Su área de distribución es el sudoeste de la península ibérica, entre Portugal España. El lince ibérico es conocido internacionalmente por el éxito en su recuperación. En 2002 solo quedaba un centenar de ejemplares y estaba considerado
La biodiversidad de España se encuentra entre las más ricas de Europa, pero también es una de las que presenta
la asignación de recursos destinados esta. Pero recuperar especies cuando están en una situación tan grave es muy complicado.
Actividades
La creación de corredores ecológicos la conservación de los hábitats naturales no solo benefician al lince ibérico, sino también muchas otras especies. La protección del conejo europeo Oryctolagus cuniculus su presa principal, ha sido esencial para garantizar una fuente de alimento estable contribuir su recuperación. Sin embargo, en algunas zonas de la península ibérica en las que los linces han desaparecido, los conejos se han convertido en una plaga.
¿Qué relación puede haber entre la desaparición del lince el aumento de la población de conejos?
¿Por qué la desaparición del lince podría suponer un peligro para la vegetación?
¿Cómo se podría resolver este desequilibrio?
¿Crees que, si se reintroducen linces en una zona, pueden llegar convertirse en animales muy abundantes?
2
Construcción del conocimiento
Contenidos organizados en ideas clave, cada una de ellas iniciada con una pregunta exploratoria que activa los conocimientos previos y guía el aprendizaje.
¿Por qué el lince solo puede vivir
El término ecología proviene de
palabras griegas oikos (‘casa’) lógos (‘estudio’). Se puede definir como la ciencia que estudia las interacciones de un organismo con otros organismos con su ambiente físico.

Especie: conjunto
1.1 ¿Qué entendemos por ecosistema? El ecosistema es la unidad básica de estudio de la ecología está formado por dos elementos: La biocenosis medio biótico. Es el conjunto de seres vivos que se encuentran en el ecosistema las interacciones que se establecen entre ellos. El biotopo medio físico. Es el espacio físico que ocupa la biocenosis los factores ambientales, como la temperatura, la luz, la humedad, la presión y la salinidad. Según las características del medio, los ecosistemas pueden ser acuáticos terrestres mixtos Uno de los objetivos de la ecología es entender la distribución la abundancia de los seres vivos en el medio físico. Por ejemplo, debería dar respuesta a esta pregunta: ¿por qué el lince solo habita en altitudes comprendidas entre los 400 los 1300 m?
Los factores abióticos
Las características fisicoquímicas del medio, conocidas como factores abióticos desempeñan un papel principal en la distribución de las especies en la definición de su hábitat es decir, el área en el que encuentran las condiciones necesarias para su desarrollo.
Cada organismo tiene unos valores óptimos un rango de tolerancia los factores abióticos, es decir, un intervalo de valores dentro del cual puede vivir y reproducirse. Esto explica por qué algunas plantas solo crecen en suelos con un pH específico o necesitan luz solar directa, mientras que otras prefieren la sombra. Si estas condiciones no se cumplen, los factores abióticos se convierten en factores limitantes afectando a la supervivencia la reproducción de las especies. Además de influir en la distribución, los factores abióticos condicionan la evolución de las especies mediante la selección natural Por ejemplo, en climas muy secos, las plantas con hojas reducidas o raíces profundas sobreviven


en cuanto clima, vegetación fauna. Los dos factores principales que definen la distribución de los biomas terrestres son la temperatura las precipitaciones A partir de ellos, se puede representar gráficamente la distribución de los biomas en la Tierra. Ciencia en contexto
1 ¿Qué encontramos en los ecosistemas? Sigue la rutina «Veo-Pienso-Me pregunto», disponible en el recurso adjunto, para analizar los ecosistemas de las imágenes. a. Describe los ecosistemas anotando los elementos y los factores que identificas en ellos. ¿Qué características se repiten en los cuatro? ¿Podemos agruparlos en alguna categoría?
b. ¿Qué factores influyen en los seres vivos que habitan en cada uno de estos ecosistemas?
c. Compara estos ecosistemas con el vertedero de la imagen adjunta. ¿Qué elementos y factores puedes observar? ¿Podemos considerar el vertedero como un ecosistema?




Síntesis gráfica de los contenidos clave trabajados, que facilitan la comprensión global, la organización de las ideas y la consolidación de los aprendizajes.
4 Resolución del reto
Actividad globalizadora final orientada a la resolución del reto, con regulación del aprendizaje y evaluación de las competencias específicas y de las competencias clave.
5 Práctica de laboratorio
Actividad experimental diseñada para aplicar los conocimientos trabajados y para favorecer el desarrollo de habilidades científicas.
6
Practicamos para la PAU
Batería final de actividades competenciales que preparan al alumnado para la resolución de la PAU.
b. Elaboraunacadenaalimentariasencillaenlaqueestén laavispaasiática tresorganismosmás.Identificael niveltróficoenelqueseencuentracadauno.
c. Imaginaquelasabejasdesaparecendebidoalapresión delaavispaasiática.¿Cómopodríaafectarestehechootrosorganismosdelacadena?¿Yalaseguridad alimentaria?Razonaturespuesta.
d. Indicacuálessonlosprincipalesciclosbiogeoquímicos queintervienenenlosecosistemasterrestres.¿Dequé modolapresenciadelaavispaasiáticapodríaafectar indirectamenteaalgunodeestosciclos?
e. ¿Creesquetodosloscambiosqueoriginaunaespecie invasorasonnegativos? Las técnicas utilizadaspararetirarlosnidosdeavispa asiáticapuedensermecánicas—cuandoelaccesoalnido esrelativamentefácil seguro—oquímicas aplicando unbiocidaenelinteriordelnido.Aunqueestas actuacionesreducenlapresenciadeesteanimal, tambiénpuedentenerconsecuenciasnodeseadas. f. Reflexionasobrelosposiblesriesgosoimpactos queestasmedidaspodríanocasionarenotrasespecies oenelconjuntodelecosistema. 3¡Losatunesestáncontaminados! Recientemente se ha alertado sobre los elevados niveles demercurioengrandespecesdepredadores como elatún,eltiburón elpezespada.
ecosistema sea estable? b. Explicadeformasecuenciadacómopuedellegar elmercurio unniño aunamujerembarazada.Utiliza laterminologíacorrespondientealflujodemateria. c. ¿Cuáldeestaspirámidescorresponde
incorporacióndemercurioenlosnivelestróficos? d. Ladosissemanaltolerabledemercurioestablecidapor laOrganizaciónMundialdelaSalud(OMS)esde1,3µg demetilmercurioporcadakilodepesocorporal.Teniendo encuentaqueunapersonaadultapesa70kg consume, aproximadamente,200gdeatún(conunaconcentración mediade1mg/kg),calculasisuperaellímitedeingesta semanaltolerable.Justificaturesultado. Seintroduceunanuevaespeciecapazdealimentarse deatunes.Justifica,entérminosdeflujodemateria energía,siestaespeciepodríasobrevivirenelecosistema yanalizacómoseveríaalteradalaredtrófica.

Biología, Geología y Ciencias Ambientales BA

Biología, Geología y Ciencias Ambientales
ISBN papel: 978-84-218-8495-9
¡NOVEDAD!

Biología 2
ISBN papel: 978-84-218-8706-6
Próximo curso 2027-2028
Todo lo que necesitas para planificar, acompañar y evaluar el aprendizaje, en tu Propuesta didáctica.


Orientaciones prácticas
Pautas metodológicas e itinerarios de personalización del aprendizaje que garantizan la inclusión de todos los alumnos. Ofrece refuerzos, ampliaciones y solucionario completo.
Programación de aula
Criterios de evaluación, competencias específicas y competencias clave, y actividades organizadas por sesiones.
Rúbricas de evaluación
Herramientas claras para valorar el progreso y las competencias del alumnado. Autoevaluación, coevaluación y heteroevaluación.
Generador de exámenes
Para crear pruebas personalizadas basadas en criterios de evaluación y en competencias. Incluye modelos sugeridos por situación de aprendizaje y por trimestre.
Guía de recursos digitales
Explicación del uso y de la finalidad de todas las herramientas.
Gestión de aula eCasals
Libro digital y seguimiento individual de los alumnos desde un único entorno.
Evaluar para aprender
26 28 Pautas DUA en acción
eCasals: tu aula digital ADA. Aprendizaje digital adaptativo


RADIX ayuda a diseñar experiencias inclusivas que eliminan barreras y que garantizan la participación de todos los alumnos.
Encontrarás estrategias para ofrecer múltiples formas de representación, acción e implicación.
Pensamiento
Hacer el pensamiento más visible, organizar las ideas y desarrollar habilidades cognitivas.


Valorar para mejorar, seguir aprendiendo y conocer los logros alcanzados.
Cooperativo
Aprender con los demás para crear juntos.

Descubre el itinerario que garantiza la evaluación de las competencias de una forma clara y sencilla.
Doble función de la evaluación competencial:
Acompaña y orienta a los alumnos durante su proceso de aprendizaje.
Y así se incorpora en cada situación de aprendizaje:
Inicio Avance
Hoja de ruta y objetivos de aprendizaje para implicar al alumnado
Diagnóstico inicial (KPSI)
Organización de las tareas (KANBAN)
Entre dos y seis actividades de desarrollo y estructuración
Estrategias de progreso: feedback, listas de verificación y bases de orientación
Autonomía y autorregulación (diario de aprendizaje)
Mediante rúbricas, reconoce los logros que han alcanzado.
Calificación
Mejora. Actividades autoevaluables
Final
Reto. Actividades de aplicación Diana de aprendizaje
Estrategias de progreso: feedback, listas de verificación y bases de orientación
Calificación
Escalera de metacognición
Tu aliado digital para enseñar y aprender sin límites.
Todo lo que necesitas para preparar tus clases, gestionar tus recursos y acompañar a tus alumnos, desde una única plataforma intuitiva y accesible.
El centro de operaciones de tu libro
• Consulta en eCasals todo el contenido de tu libro cuando lo necesites.
• Accede a las programaciones, a la propuesta didáctica y a las actividades adicionales.
Vive una experiencia más enriquecedora en el aula
• Proyecta los contenidos del libro y descubre la facilidad del formato digital con HTML integrado.
• Motiva a tus alumnos con recursos interactivos y dinámicos. ¡NOVEDAD!


Personaliza el aprendizaje
• Combina actividades y recursos para crear tareas adaptadas a tus alumnos y a tu manera de enseñar.
Diseña tu propia experiencia
• Crea tus propias actividades, sube tus materiales y organiza tus recursos con las herramientas de eCasals.
Integrado en las principales plataformas
• eCasals se integra fácilmente en Moodle, Classroom, Teams y otros entornos educativos a través de Marsupial y LTI.
• También dispone de una versión integrada en Blinklearning.
Nuestro equipo de asesores digitales te ofrece formación personalizada, webinars prácticos y un servicio de soporte técnico cercano y eficaz.

Aprovecha al máximo tus herramientas digitales.

Siempre a tu disposición en docencia@editorialcasals.com
ADA Casals es el ecosistema de aprendizaje digital de Biología y Geología, diseñado para acompañar a alumnos y a docentes en un entorno completo, interconectado y adaptativo.

1
Engage
Descubre
Activación de conocimientos previos mediante vídeos y retos contextualizados.

2
Explore Construye
Aprendizaje activo a partir de situaciones de aprendizaje que fomentan la investigación y el descubrimiento.

Explain Organiza 3
Sistematización y representación visual de los saberes adquiridos.

Elaborate Aplica 4
Transferencia del aprendizaje a contextos reales.

5
Evaluate Evalúa
Evaluación competencial a través de actividades contextualizadas.


Libro digital con diferentes niveles de lectura
Se exponen los contenidos básicos e imprescindibles que se deben trabajar acompañados de recursos (simuladores, animaciones, tutoriales y vídeos de experimentos) que permiten ampliar conocimientos y familiarizarse con los conceptos más abstractos.

Biología y Geología 1
ISBN digital: 978-84-218-7363-2
Biology and Geology 1
ISBN digital: 978-84-218-7364-9
Disponible también en inglés para centros bilingües
Libro guía. Manual en papel y ejercicios resueltos paso a paso
Libro de aprendizaje que contiene infografías y resúmenes de los conceptos teóricos de cada situación.



Biología y Geología 3
ISBN digital: 978-84-218-7366-3
Biology and Geology 3
ISBN digital: 978-84-218-7367-0

Biología y Geología 4
ISBN digital: 978-84-218-7369-4
Biology and Geology 4
ISBN digital: 978-84-218-7370-0

Biología y Geología 1
ISBN papel: 978-84-218-7513-1

Biology and Geology 1
ISBN papel: 978-84-218-7514-8


Biología y Geología 3
ISBN papel: 978-84-218-7516-2

Biology and Geology 3
ISBN papel: 978-84-218-7517-9

Biología y Geología 4
ISBN papel: 978-84-218-7519-3

Biology and Geology 4
ISBN papel: 978-84-218-7520-9

Guia pedagógica
Guía pedagógica integrada en cada diapositiva, solucionarios y programaciones de aula adaptadas a la LOMLOE.
Herramientas intuitivas de gestión del aula
Organización del aula mediante tablas de calificación, seguimiento del progreso del alumnado, itinerarios personalizados y una presentación clara y estructurada de los contenidos.


Visita editorialcasals.com/ada y accede a una demo

Evaluación competencial
Actividades etiquetadas con las competencias de la asignatura que permiten una evaluación automatizada y competencial de los saberes

Propuestas de exámenes trimestrales y de unidad
Modelos de examen por competencias específicas y por criterios de evaluación, conectados con los descriptores del perfil de salida del alumnado

Rúbricas de evaluación
Incluye rúbricas de evaluación formativa para guiar el aprendizaje del alumnado y para facilitar la autorreflexión y su implicación activa.
